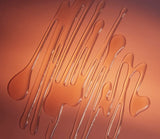

ALPINE ROSE NECTAR MASK
HYDRATE, SOOTHE, AND BOOST LUMINOSITY
Infused with precious Ruby Powder, stem cells from the treasured Alpine Rose, a proprietary peptide-ferment, and an abundance of moisture factors and nutrients, this unconventional nectar mask provides instant hydration, leaving skin velvety soft, smooth, and luminous.
Benefits:
- Energizes and brightens leaving skin with a healthy glow.
- Hydrates for an instantly supple and smooth complexion.
- Cools and refines, improving skin texture, tone and radiance.
Ways to Use:
- Apply thin layer with brush and leave on for 15-20 min.
- Refrigerate Glacial Masque to get greater soothing and firming.
- Use after Micro-Exfoliating Cleanser or Au Vin Pads for a mini facial treatment.
- Use a GuaSha stone or jade to apply for enhanced micro-circulation and absorption.
Ideal For:
- All skin types. Dry, Oily, Combination, and Sensitive.
Includes Luzern mask brush | Vegetarian Formula
3.3 FL. OZ. | 60 ML.
Giving back 3% of profits: 1% for Planet 1% for People 1% for Peace
Key IngredientsRuby Powder, Alpine Rose Stem Cells, Oligo-Peptide, Squalane, Hyaluronic Acid, Panthenol (Vitamin B5), Willow Bark Extract, Organic Aloe, Organic Honey
GLUTEN FREE | VEGETARIAN FORMULA
Ingredients: Glycerin**†, Caprylic/Capric Triglyceride*†, Squalane*†, Propanediol*†, Panthenol*†, Aloe Barbadensis Leaf Juice**†, Sodium Hyaluronate*†, Rhododendron Ferrugineum Leaf Cell Culture Extract*†, Malva Sylvestris (Mallow) Flower/Leaf/Stem Extract**†, Salix Alba (Willow) Bark Extract*†, Saccharomyces Ferment Filtrate*†, Hamamelis Virginiana (Witch Hazel) Water*†, *†, Ruby Powder*†, Honey**†, Kaolin*†, Water (Aqua)*†, Yeast Ferment Extract*†, 1,2-Hexanediol†, Soy Amino Acids*†, Sodium Acrylates Copolymer†, Isomalt*†, Ethylhexylglycerin*†, Lactic Acid*†, Hydroxyacetophenone*†, Sodium Benzoate*†, Citrus Sinensis (Sweet Orange) Peel Oil**†, Lecithin*†, Tetrasodium Glutamate Diacetate*†, Potassium Sorbate*†.
* NATURALDERIVED/DÉRIVÉS DE NATUREL
** CERTIFIED ORGANIC/CERTIFIÉ ORGANIQUE
† LOW HAZARD RATING OF “GREEN”